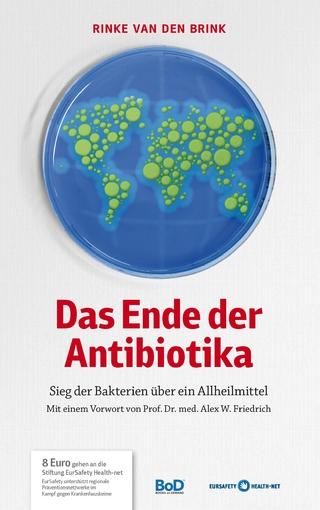
Das Ende der Antibiotika

Zur Geschichte der synthetischen Antimalariamittel
Buch | Softcover
2014
|
Auflage:
1
|
Wissenschaftliche..
ISBN: 9783804733008
CHF 37,80 (inkl. MwSt)
- Versand in
10-15 Tagen